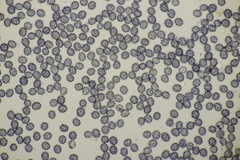
Russula subfoetens
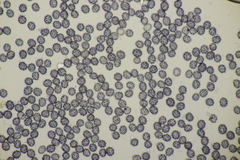
Russula subfoetens
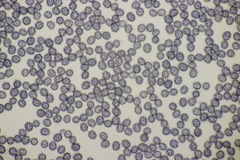
Russula subfoetens

Russula subfoetens: taxon details and analytics
- Domain
- Kingdom
- Fungi
- Phylum
- Basidiomycota
- Class
- Agaricomycetes
- Order
- Russulales
- Family
- Russulaceae
- Genus
- Russula
- Species
- Russula subfoetens
- Scientific Name
- Russula subfoetens
Summary description from Wikipedia:
Russula subfoetens in languages:
- Bokmål
- gulnende stankkremle
- Czech
- holubinka páchnoucí
- Danish
- Honninggul skørhat
- Dutch
- Vergelende stinkrussula
- Finnish
- valehaisuhapero
- German
- Gilbender Stinktäubling
- Lithuanian
- Šleikščioji ūmėdė
- Russian
- Подвалуй
- Swedish
- gulnande stinkkremla
Images from inaturalist.org observations:
We recommend you sign up for this excellent, free service.
Parent Taxon
Sibling Taxa
- Foetentinae
- Oleiferinae
- Pectinatinae
- Russula ahmadii
- Russula amerorecondita
- Russula ammophila
- Russula arunii
- Russula catillus
- Russula cerolens
- Russula clavulus
- Russula echidna
- Russula fluvialis
- Russula foetentoides
- Russula foetentula
- Russula fragrantissima
- Russula garyensis
- Russula gelatinosa
- Russula granulata
- Russula hainanensis
- Russula hortensis
- Russula indocatillus
- Russula multilamellula
- Russula mutabilis
- Russula nondistincta
- Russula obscuricolor
- Russula ombrophila
- Russula pilosella
- Russula pseudocatillus
- Russula punctipes
- Russula recondita
- Russula rufobasalis
- Russula senecis
- Russula straminella
- Russula subfoetens
- Russula subpectinatoides
- Russula subpunctipes
- Russula succinea
- Russula ventricosipes
- Russula vinaceocuticulata
- Subvelatae